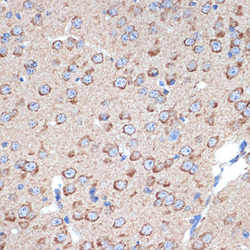

STJ11103124
antibody from St John's Laboratory
Targeting: ERP29
C12orf8, ERp28, ERp31, PDI-DB, PDIA9
Antibody data
- Antibody Data
- Antigen structure
- References [0]
- Comments [0]
- Validations
- Western blot [1]
- Immunohistochemistry [3]
Submit
Validation data
Reference
Comment
Report error
- Product number
- STJ11103124 - Provider product page

- Provider
- St John's Laboratory
- Product name
- Anti-ERp29 antibody (STJ11103124)
- Antibody type
- Monoclonal
- Description
- Rabbit monoclonal antibody anti-ERp29 is suitable for use in Western Blot and Immunohistochemistry.
- Reactivity
- Human, Mouse, Rat
- Host
- Rabbit
- Conjugate
- Unconjugated
- Antigen sequence
NA- Epitope
- NA
- Isotype
- IgG
- Antibody clone number
- NA
- Vial size
- NA
- Concentration
- NA
- Storage
- Store in a freezer at-20°C and avoid freeze-thaw cycles.
- Handling
- NA
No comments: Submit comment
Supportive validation
- Submitted by
- St John's Laboratory (provider)
- Main image

- Experimental details
- Western blot analysis of extracts of various cell lines, using ERp29 rabbit monoclonal antibody (STJ11103124) at 1:1000 dilution. Secondary antibody: HRP Goat Anti-rabbit IgG (H+L) at 1:10000 dilution. Lysates/proteins: 25ug per lane. Blocking buffer: 3% nonfat dry milk in TBST. Detection: ECL Basic Kit. Exposure time: 180s.
- Sample type
- NA
- Validation comment
- NA
- Primary Ab dilution
- NA
- Other comments
- NA
- Secondary Ab
- NA
- Secondary Ab dilution
- NA
- Protocol
- NA
Supportive validation
Supportive validation
Supportive validation
- Submitted by
- St John's Laboratory (provider)
- Main image

- Experimental details
- Immunohistochemistry of paraffin-embedded rat lung using ERp29 rabbit monoclonal antibody (STJ11103124) at dilution of 1:100 (40x lens).
- Sample type
- NA
- Validation comment
- NA
- Primary Ab dilution
- NA
- Other comments
- NA
- Secondary Ab
- NA
- Secondary Ab dilution
- NA
- Protocol
- NA
Supportive validation
- Submitted by
- St John's Laboratory (provider)
- Main image

- Experimental details
- Immunohistochemistry of paraffin-embedded human placenta using ERp29 rabbit monoclonal antibody (STJ11103124) at dilution of 1:100 (40x lens).
- Sample type
- NA
- Validation comment
- NA
- Primary Ab dilution
- NA
- Other comments
- NA
- Secondary Ab
- NA
- Secondary Ab dilution
- NA
- Protocol
- NA
Supportive validation
- Submitted by
- St John's Laboratory (provider)
- Main image
- Experimental details
- Immunohistochemistry of paraffin-embedded mouse brain using ERp29 rabbit monoclonal antibody (STJ11103124) at dilution of 1:100 (40x lens).
- Sample type
- NA
- Validation comment
- NA
- Primary Ab dilution
- NA
- Other comments
- NA
- Secondary Ab
- NA
- Secondary Ab dilution
- NA
- Protocol
- NA
 Explore
Explore Validate
Validate Learn
Learn Western blot
Western blot